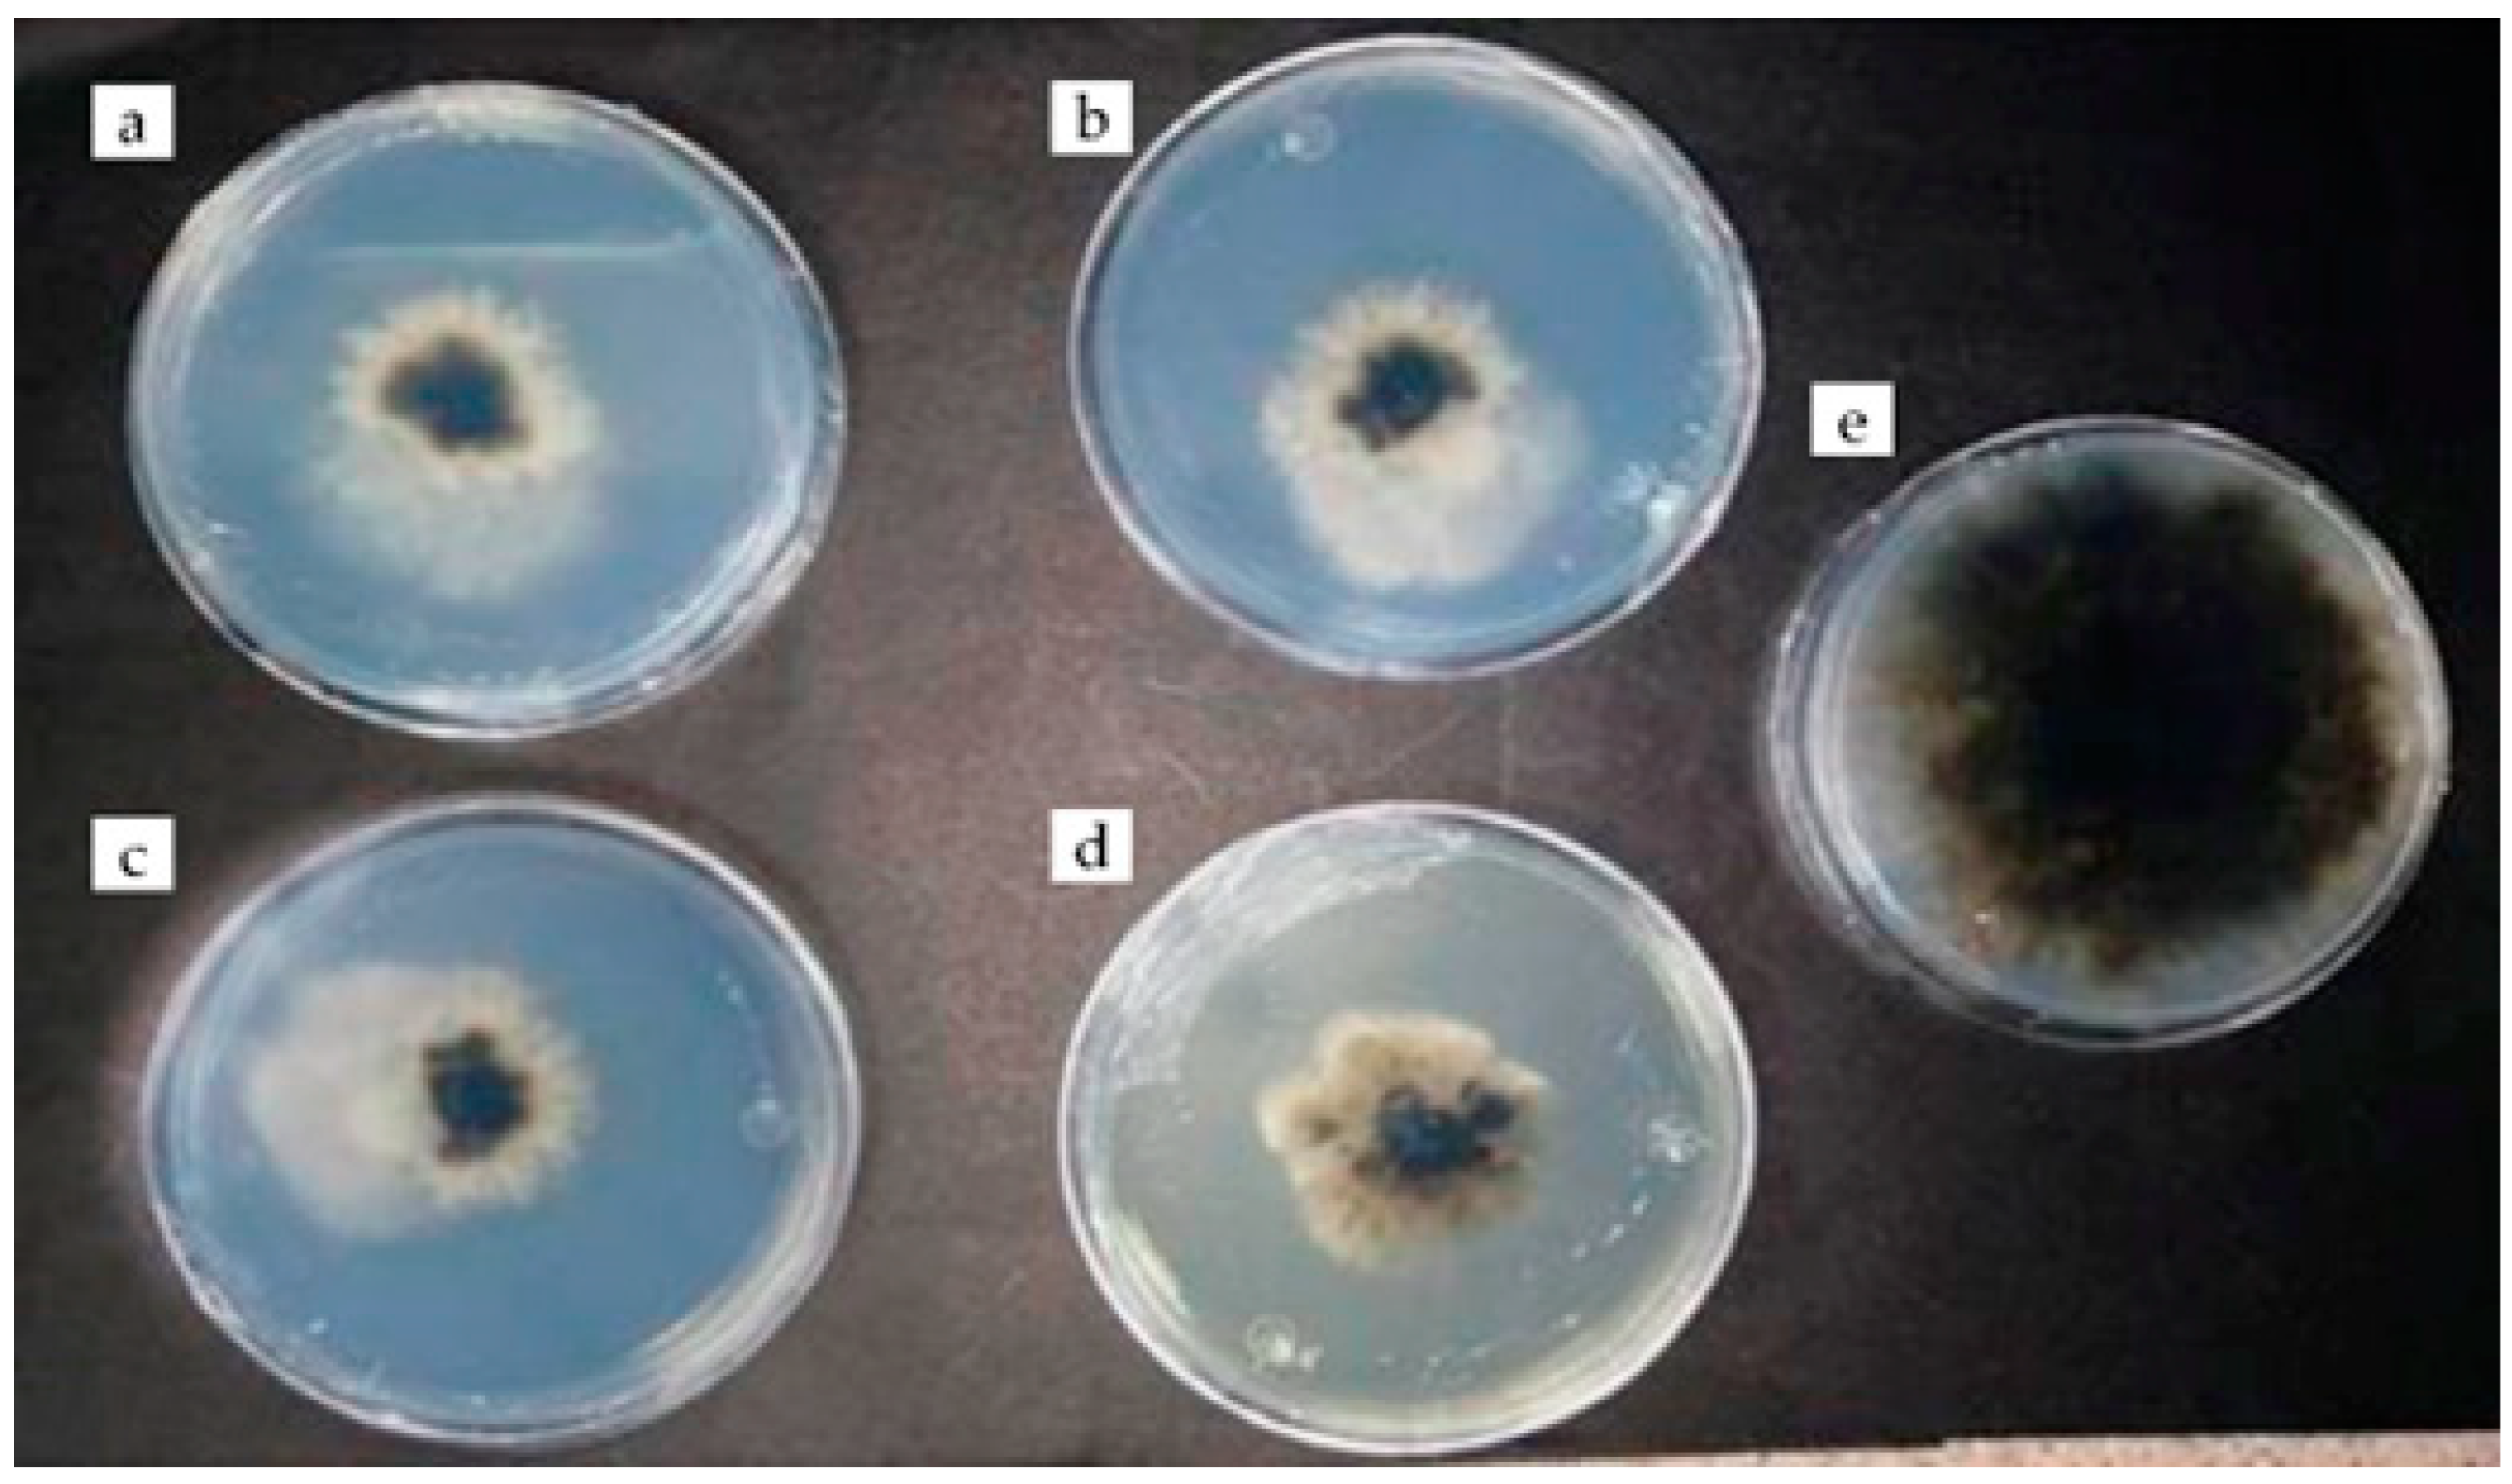
Plants 12 03416 g002 Plants 12 03416 g002

Antifungal Activity of Rue Essential Oil and Commercial Chitosan on Native Corn Foliar Diseases
Abstract
1. Introduction
2. Results
2.1. Incidence and Severity of Foliar Diseases
2.2. In Vitro Fungal Inhibition
2.2.1. Percentage of Inhibition of C. phyllachorae
2.2.2. Percentage Inhibition of E. turcicum
2.3. Secondary Metabolites of Rue Essential Oil
3. Materials and Methods
3.1. Obtaining Rue Plants and Phytopathological Sampling Sites
3.2. Isolation and Identification of Fungi
3.3. Obtaining Rue Essential Oil
3.4. Inhibition of the Growth of Phytopathogenic Fungi In Vitro
3.5. Preparation of Chitosan Solution
3.6. Preparation of Benomyl 50% PW p/p (500 g/kg)
3.7. Identification of Secondary Metabolites of Rue Oil
3.8. Data Analysis
4. Conclusions
Author Contributions
Funding
Data Availability Statement
Acknowledgments
Conflicts of Interest
References
- Rivadeneira, T.G.; Villamar, A.A. “En Cherán Nadie se Muere de Hambre”: Aportes de la Etnobiología a la Seguridad Alimentaria “in Cherán No One Dies of Hunger”: Ethnobiology Contributions to Food Security. Espac. Reg. 2016, 1, 81–93. [Google Scholar]
- Félix-Gastélum, R.; Lizárraga-Sánchez, G.J.; Maldonado-Mendoza, I.E.; Leyva-Madrigal, K.Y.; Herrera-Rodríguez, G.; Espinoza-Matías, S. Confirmación de la Identidad de Exserohilum turcicum, Agente Causal del Tizón Foliar del Maíz en Sinaloa. Rev. Mex. Fitopatol. Mex. J. Phytopathol. 2018, 36, 468–478. [Google Scholar] [CrossRef]
- Ríos-Herrera, E.N.; Ochoa-Fuentes, Y.M.; Cerna-Chávez, E.; Landeros-Flores, J.; Cepeda-Siller, M.; Rodríguez-Guerra, R. Hongos Asociados a la Mancha de Asfalto en el Cultivo de Maíz en México. Rev. Mex. Ciencias Agrícolas 2017, 8, 457–462. [Google Scholar] [CrossRef][Green Version]
- Orduño-Cota, F.J.; Montiel-García, M.A.; Herrera-Rodríguez, G.; Ruíz-Guzmán, A.G.; Espinoza-Castillo, D.F.; Ruiz-Guzmán, A.G.; Rochín-Zepeda, Y.; Montiel-García, M.A.; Gálvez-Figueroa, C.A.; Espinoza-Navarro, C.R.; et al. Distribución, Incidencia, Severidad y Control del Tizón Foliar del Maíz en el Norte de Sinaloa. CESAVESIN Fitosanidad Inocuidad Sinaloa 2015, 3, 1–41. [Google Scholar]
- Pereyda-Hernández, J.; Hernández-Morales, J.; Sandoval-Islas, J.S.; Aranda-Ocampo, S.; de León, C.; Gómez-Montiel, N. Etiología y Manejo de la Mancha de Asfalto (Phyllachora maydis Maubl.) del Maíz en Guerrero, México. Agrociencia 2009, 43, 511–519. [Google Scholar]
- Bajet, N.B.; Renfro, B.L.; Carrasco, J.M.V. Control of Tar Spot of Maize and Its Effect on Yield. Int. J. Pest Manag. 1994, 40, 121–125. [Google Scholar] [CrossRef]
- Martínez-Sánchez, J.; Espinosa-Paz, N. Sugerencias Para el Control del Complejo Mancha de Asfalto del Maíz en la Frailesca, Chiapas. Foll. Para Prod. 2014, 13, 15. [Google Scholar] [CrossRef]
- García-Hernández, J.; Leyva-Morales, J.B.; Martínez-Rodríguez, I.E.; Hernández-Ochoa, M.I.; Aldana-Madrid, M.L.; Rojas-García, A.E.; Betancourt-Lozano, M.; Perez-Herrera, N.E.; Perera-Rios, J.H. Estado Actual de la Investigación Sobre Plaguicidas en México. Rev. Int. Contam. Ambient. 2018, 34, 29–60. [Google Scholar] [CrossRef]
- Vargas-González, G.; Alvarez-Reyna, V.D.P.; Guigón-López, C.; Cano-Ríos, P.; García-Carrillo, M. Impacto Ambiental Por Uso de Plaguicidas en Tres Áreas de Producción de Melón en la Comarca Lagunera, México. CienciaUAT 2019, 13, 113. [Google Scholar] [CrossRef]
- Ribeiro-Chagas, J.F.; Véras da Costa, R.; Rodríguez-dos Santos, G.; Abadía-Ventura, M.V.; Costa, E.M. Foliar Fungal Diseases Control and Productivity Depending on the Phosphite and Fungicide Application in Two Corn Hybrids. Biotecnol. Veg. 2020, 20, 33–41. [Google Scholar]
- Storck, V.; Karpouzas, D.G.; Martin-Laurent, F. Towards a Better Pesticide Policy for the European Union. Sci. Total Environ. 2017, 575, 1027–1033. [Google Scholar] [CrossRef] [PubMed]
- Jiménez-Reyes, M.F.; Carrasco, H.; Olea, A.F.; Silva-Moreno, E. Natural Compounds: A Sustainable Alternative to the Phytopathogens Control. J. Chil. Chem. Soc. 2019, 64, 4459–4465. [Google Scholar] [CrossRef]
- López-Díaz, S.; Sandoval-Flores, M.G.; Flores-Pantoja, L.E.; Jiménez-Mejía, R.; Santoyo, G.; Loeza-Lara, P.D. Quitosanos y compósito quitosano-octanoato de sodio reducen la pudrición de fresa en poscosecha. Revista Mexicana de Ciencias Agrícolas 2021, 12, 1131–1137. [Google Scholar] [CrossRef]
- Di Meng, D.; Betchem, G.; Ren, Y.; Yao, M.; Xia, X.; Li, M.; Wang, Y. Antifungal activity of chitosan against Aspergillus ochraceus and its possible mechanisms of action. Int. J. Biol. Macromol. 2020, 158, 1063–1070. [Google Scholar] [CrossRef] [PubMed]
- Lopez-Moya, F.; Suarez-Fernandez, M.; Lopez-Llorca, L.V. Molecular Mechanisms of Chitosan Interactions with Fungi and Plants. Int. J. Mol. Sci. 2019, 20, 332. [Google Scholar] [CrossRef]
- Ramírez-Hernández, D.M. Identificación e Incidencia y Severidad del Tizón Norteño del Maíz en el Ejido del Prado, Galeana, Nuevo León; Universidad Autónoma Agraria Antonio Narro: Saltillo, México, 2014. [Google Scholar]
- Varón de Agudelo, F.; Sarria Villa, G.A. Enfermedades del Maíz y Su Manejo; Diagramación, I.y.E., Ed.; Grupo Tran; Instituto Colombiano Agropecuario, ICA y de la Federación Nacional de Cultivadores de Cereales y Leguminosas, Fenalce: Bogotá, Colombia, 2007; Volume 64, ISBN 9789589790236. [Google Scholar]
- Hernández-Ramos, L.; Sandoval-Islas, J.S. Escala Diagramática de Severidad Para el Complejo Mancha de Asfalto del Maíz. Rev. Mex. Fitopatol. 2015, 33, 95–103. [Google Scholar]
- Puerto-Hernández, C.E.; Avellaneda, C. Epidemiología de la Mancha de Asfalto en Maíz Bajo Diferentes Estrategias de Manejo. CEIBA Zamor. Investig. 2021, 0851, 65–82. [Google Scholar]
- Peterson, R.F.; Campbell, A.B.; Hannah, A.E. A Diagrammatic Scale for Estimating Rust Intensity on Leaves and Stems of Cereals. Can. J. Res. 1948, 26, 496–500. [Google Scholar] [CrossRef]
- Programa de Maíz del CIMMYT. Enfermedades del Maíz: Una Guía Para su Identificación en el Campo; Cuarta edición; Centro Internacional de Mejoramiento de Maíz y Trigo (CIMMYT): Texcoco, Mexico, 2004; ISBN 9706481281. [Google Scholar]
- Guédez, C.; Cañizalez, L.; Avendaño, L.; Scorza, J.; Castillo, C.; Olivar, R.; Méndez, Y.; Sánchez, L. Actividad Antifúngica del Aceite Esencial de Naranja (Citrus sinensis L.) Sobre Hongos Postcosecha en Frutos de Lechosa (Carica papaya L.). Rev. Soc. Ven. Microbiol. 2014, 34, 81–87. [Google Scholar]
- Gandarilla-Pacheco, F.L.; Torres-Caraballo, S.; de Luna-Santillana, E.J.; Quintero-Zapata, I.; Arroyo-González, N. Efecto Inhibitorio de Aceites Esenciales en el Crecimiento Micelial de Penicillium gigitatum (PERS.) SACC. Aislado de Naranja Dulce (Citrus sinensis Osbeck). Agrociencia 2020, 54, 209–225. [Google Scholar]
- Haddouchi, F.; Chaouche, T.M.; Zaouali, Y.; Ksouri, R.; Attou, A.; Benmansour, A. Chemical Composition and Antimicrobial Activity of the Essential Oils from Four Ruta Species Growing in Algeria. Food Chem. 2013, 141, 253–258. [Google Scholar] [CrossRef]
- Chávez-Magdaleno, M.E.; Gutiérrez-Martínez, P.; Montaño-Leyva, B.; González-Estrada, R.R. Evaluación In Vitro del Quitosano y Aceites Esenciales Para el Control de dos Especies Patógenas de Colletotrichum Aisladas de Aguacate (Persea americana Mill). TIP Rev. Espec. Ciencias Químico-Biológicas 2019, 22, 1–8. [Google Scholar] [CrossRef]
- Velásquez, M.; Álvarez, R.; Tamayo, P.; Carvalho, C. Evaluación In Vitro de la Actividad Fungistática del Aceite Esencial de Mandarina Sobre el Crecimiento de Penicillium sp. Cienc. Tecnol. Agropecu. 2015, 15, 7–14. [Google Scholar] [CrossRef]
- Scalvenzi, L.; Yaguache, B.; Cabrera, P.; Guerrini, A. Actividad Antifúngica In Vitro de Aceites. Bioagro 2016, 28, 39–46. [Google Scholar]
- Sharma, K.S.; Kumar, S.; Chand, K.; Kathuria, A.; Gupta, A.; Jain, R. An Update on Natural Occurrence and Biological Activity of Chromones. Curr. Med. Chem. 2011, 18, 3825–3852. [Google Scholar] [CrossRef] [PubMed]
- Díaz, M. Determination of the Yield at Different Extraction Times of the Essential Oil of the Root Salvia trifilis Epling (Mejorana) by the Steam Trapping Method. Agroindustrial Sci. 2017, 7, 73–77. [Google Scholar] [CrossRef]
- Pino, O.; Sánchez, Y.; Rojas, M.M.; Abreu, Y.; Correa, T.M. Composición Química y Actividad Antibacteriana del Aceite Esencial de Ruta chalepensis L. Chemical Composition and Antibacterial Activity of the Essential Oil from Ruta chalepensis L. Rev. Protección Veg 2014, 29, 220–225. [Google Scholar]
- Nahar, L.; El-Seedi, H.R.; Khalifa, S.A.M.; Mohammadhosseini, M.; Sarker, S.D. Ruta Essential Oils: Composition and Bioactivities. Molecules 2021, 26, 4766. [Google Scholar] [CrossRef]
- Semerdjieva, I.B.; Burducea, M.; Astatkie, T.; Zheljazkov, V.D.; Dincheva, I. Essential Oil Composition of Ruta graveolens L. Fruits and Hyssopus officinalis subsp. Aristatus (Godr.) Nyman Biomass as a Function of Hydrodistillation Time. Molecules 2019, 24/22, 4047. [Google Scholar] [CrossRef]
- Ellis, G.P. Naturally Occurring Chromones. In Chemistry of Heterocyclic Compounds: A Series of Monographs; Ellis, G.P., Ed.; John Wiley & Sons, Ltd.: Hoboken, NJ, USA, 2008; Volume 31, pp. 455–480. [Google Scholar]
- Walters, D.; Raynor, L.; Mitchell, A.; Walker, R.; Walker, K. Antifungal Activities of Four Fatty Acids against Plant Pathogenic Fungi. Mycopathologia 2004, 157, 87–90. [Google Scholar] [CrossRef]
- Guimarães, A.; Venâncio, A. The Potential of Fatty Acids and Their Derivatives as. Toxins 2022, 14, 188. [Google Scholar] [CrossRef]
- Campione, E.; Gaziano, R.; Doldo, E.; Marino, D.; Falconi, M.; Iacovelli, F.; Tagliaferri, D.; Pacello, L.; Bianchi, L.; Lanna, C.; et al. Antifungal Effect of All-Trans Retinoic Acid against Aspergillus fumigatus In Vitro and in a Pulmonary Aspergillosis In Vivo Model. Antimicrob. Agents Chemother. 2021, 65, e01874-20. [Google Scholar] [CrossRef] [PubMed]
- INEGI Anuario Estadístico y Geográfico de Michoacán de Ocampo 2017. Inst. Nac. Estadística y Geogr. 2018, 10, 132.
- Duarte, Y.; Pino, O.; Infante, D.; Sánchez, Y.; Travieso, C.; Martínez, B. Efecto In Vitro de Aceites Esenciales Sobre Alternaria solani Sorauer. Rev. Protección Veg. 2013, 28, 54–59. [Google Scholar]
- Ezziyyani, M.; Sánchez, C.P.; Requena, M.E.; Rubio, L.; Candela, M.E. Biocontrol por Streptomyces rochei–Ziyani–, de la Podredumbre del Pimiento (Capsicum annuum L.) Causada por Phytophthora capsici. An. De Biol. 2004, 26, 69–78. [Google Scholar]
- Díaz-Montes, E.; Barragán-Huerta, B.E.; Yáñez-Fernández, J. Identification and Evaluation of Antioxidant Activity of Hydroxycinnamic Acids Extracted by Ultrafiltration from Three Varieties of Mexican Maize. Waste Biomass Valorization 2020, 11, 1799–1808. [Google Scholar] [CrossRef]

| Percentage of Inhibition (%) | ||||||||
|---|---|---|---|---|---|---|---|---|
| Treatments | 24 h | 48 h | 72 h | 96 h | 120 h | 144 h | 168 h | 192 h |
| Benomyl (5 μL) | 100 ± 0.0 a | 100 ± 0.0 a | 100 ± 0.0 a | 100 ± 0.0 a | 100 ± 0.0 a | 98 ± 2.3 a | 95 ± 1.5 a | 91 ± 3.7 a |
| Benomyl (10 μL) | 100 ± 0.0 a | 100 ± 0.0 a | 100 ± 0.0 a | 100 ± 0.0 a | 100 ± 0.0 a | 100 ± 0.0 a | 99 ± 1.5 a | 94 ± 2.4 a |
| Chitosan (5 μL) | 94 ± 7.3 a | 73 ± 11.0 b | 65 ± 6.7 b | 60 ± 3.8 b | 57 ± 3.8 b | 48 ± 4.7 b | 43 ± 5.1 b | 37 ± 5.5 b |
| Chitosan (10 μL) | 100 ± 0.0 a | 73 ± 9.9 b | 65 ± 8.4 b | 43 ± 4.0 c | 41 ± 5.2 c | 38 ± 6.5 c | 30 ± 4.9 c | 25 ± 2.0 c |
| Rue essential oil (3 μL) | 100 ± 0.0 a | 100 ± 0.0 a | 100 ± 0.0 a | 100 ± 0.0 a | 100 ± 0.0 a | 100 ± 0.0 a | 100 ± 0.0 a | 100 ± 0.0 a |
| Percentage of Inhibition (%) | ||||||||
|---|---|---|---|---|---|---|---|---|
| Treatments | 24 h | 48 h | 72 h | 96 h | 120 h | 144 h | 168 h | 192 h |
| Benomyl (5 μL) | 75 ± 10.3 b | 49 ± 5.7 c | 27 ± 3.2 c | 29 ± 3.8 c | 19 ± 2.4 d | 18 ± 2.4 d | 17 ± 2.0 c | 16 ± 3.5 c |
| Benomyl (10 μL) | 88 ± 10.2 a | 84 ± 4.0 b | 74 ± 6.0 b | 63 ± 9.8 b | 56 ± 4.2 c | 46 ± 3.5 c | 37 ± 3.8 b | 35 ± 5.5 b |
| Chitosan (5 μL) | 100 ± 0.0 a | 94 ± 4.0 a | 93 ± 4.5 a | 96 ± 3.0 a | 95 ± 2.0 ab | 92 ± 1.5 b | 91 ± 2.0 a | 89 ± 6.1 a |
| Chitosan (10 μL) | 100 ± 0.0 a | 100 ± 0.0 a | 96 ± 4.6 a | 96 ± 2.5 a | 96 ± 3.2 ab | 94 ± 2.0 ab | 91 ± 2.0 a | 88 ± 4.0 a |
| Rue essential oil (3 μL) | 100 ± 0.0 a | 100 ± 0.0 a | 100 ± 0.0 a | 100 ± 0.0 a | 100 ± 0.0 a | 98 ± 2.8 a | 96 ± 1.1 a | 96 ± 2.4 a |
| Molecule | Mass Charge Ratio | Volatility |
|---|---|---|
| Cinnamoyl chromone * | 277.0831 m/z | Semi-volatile |
| Palmitic acid | 255.2318 m/z | Non-volatile |
| Linoleic acid | 277.2165 m/z | Non-volatile |
| Retinoic acid | 299.2012 m/z | Non-volatile |
Disclaimer/Publisher’s Note: The statements, opinions and data contained in all publications are solely those of the individual author(s) and contributor(s) and not of MDPI and/or the editor(s). MDPI and/or the editor(s) disclaim responsibility for any injury to people or property resulting from any ideas, methods, instructions or products referred to in the content. |
© 2023 by the authors. Licensee MDPI, Basel, Switzerland. This article is an open access article distributed under the terms and conditions of the Creative Commons Attribution (CC BY) license (https://creativecommons.org/licenses/by/4.0/).
Share and Cite
Ceja-Torres, L.F.; López-Díaz, S.; Silva-Ramos, M.G.; Silva-García, J.T.; Medina-Medrano, J.R.; Gutiérrez-Hernández, G.F. Antifungal Activity of Rue Essential Oil and Commercial Chitosan on Native Corn Foliar Diseases. Plants 2023, 12, 3416. https://doi.org/10.3390/plants12193416
Ceja-Torres LF, López-Díaz S, Silva-Ramos MG, Silva-García JT, Medina-Medrano JR, Gutiérrez-Hernández GF. Antifungal Activity of Rue Essential Oil and Commercial Chitosan on Native Corn Foliar Diseases. Plants. 2023; 12(19):3416. https://doi.org/10.3390/plants12193416
Chicago/Turabian StyleCeja-Torres, Luis Fernando, Sigifredo López-Díaz, María Guadalupe Silva-Ramos, José Teodoro Silva-García, José Roberto Medina-Medrano, and Germán Fernando Gutiérrez-Hernández. 2023. "Antifungal Activity of Rue Essential Oil and Commercial Chitosan on Native Corn Foliar Diseases" Plants 12, no. 19: 3416. https://doi.org/10.3390/plants12193416
APA StyleCeja-Torres, L. F., López-Díaz, S., Silva-Ramos, M. G., Silva-García, J. T., Medina-Medrano, J. R., & Gutiérrez-Hernández, G. F. (2023). Antifungal Activity of Rue Essential Oil and Commercial Chitosan on Native Corn Foliar Diseases. Plants, 12(19), 3416. https://doi.org/10.3390/plants12193416

